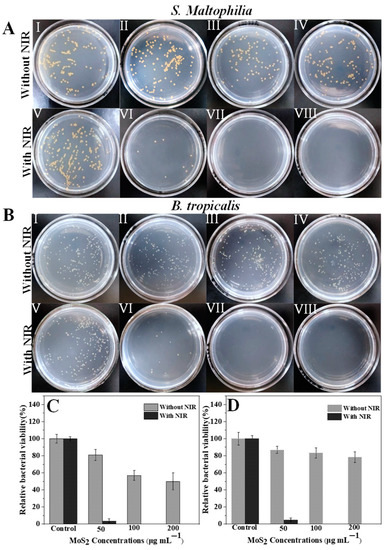
Nanomaterials 13 00824 g006 550

Error in Figure
In the original publication [1], there was a mistake in Figure 6A II as published. A duplicate of the image for Figure 6A III was selected in error. The corrected Figure 6A II appears below. The scientific conclusions are unaffected. This correction was approved by the Academic Editor. The original publication has also been updated.
Original image (incorrect one):

Corrected Figure 6:
Figure 6.
Photographs of bacterial colonies formed by (A) S. Maltophilia and (B) B. tropicalis after exposed to (I) PBS, (II) 50 μg/mL PEG-MoS2 NFs, (III) 100 μg/mL PEG-MoS2 NFs, (IV) 200 μg/mL PEG-MoS2 NFs, (V) PBS + NIR, (VI) 50 μg/mL PEG-MoS2 NFs + NIR, (VII) 100 μg/mL PEG-MoS2 NFs + NIR, (VIII) 200 μg/mL PEG-MoS2 NFs + NIR; The relative viability of (C) S. Maltophilia and (D) B. tropicalis after heat treatment with 808 nm NIR light for 10 min was measured by plate counting (Error bars are standard deviations of three parallel experiments).
Figure 6.
Photographs of bacterial colonies formed by (A) S. Maltophilia and (B) B. tropicalis after exposed to (I) PBS, (II) 50 μg/mL PEG-MoS2 NFs, (III) 100 μg/mL PEG-MoS2 NFs, (IV) 200 μg/mL PEG-MoS2 NFs, (V) PBS + NIR, (VI) 50 μg/mL PEG-MoS2 NFs + NIR, (VII) 100 μg/mL PEG-MoS2 NFs + NIR, (VIII) 200 μg/mL PEG-MoS2 NFs + NIR; The relative viability of (C) S. Maltophilia and (D) B. tropicalis after heat treatment with 808 nm NIR light for 10 min was measured by plate counting (Error bars are standard deviations of three parallel experiments).

Reference
- Liu, L.; Wu, W.; Fang, Y.; Liu, H.; Chen, F.; Zhang, M.; Qin, Y. Functionalized MoS2 Nanoflowers with Excellent Near-Infrared Photothermal Activities for Scavenging of Antibiotic Resistant Bacteria. Nanomaterials 2021, 11, 2829. [Google Scholar] [CrossRef] [PubMed]
Disclaimer/Publisher’s Note: The statements, opinions and data contained in all publications are solely those of the individual author(s) and contributor(s) and not of MDPI and/or the editor(s). MDPI and/or the editor(s) disclaim responsibility for any injury to people or property resulting from any ideas, methods, instructions or products referred to in the content. |
© 2023 by the authors. Licensee MDPI, Basel, Switzerland. This article is an open access article distributed under the terms and conditions of the Creative Commons Attribution (CC BY) license (https://creativecommons.org/licenses/by/4.0/).
